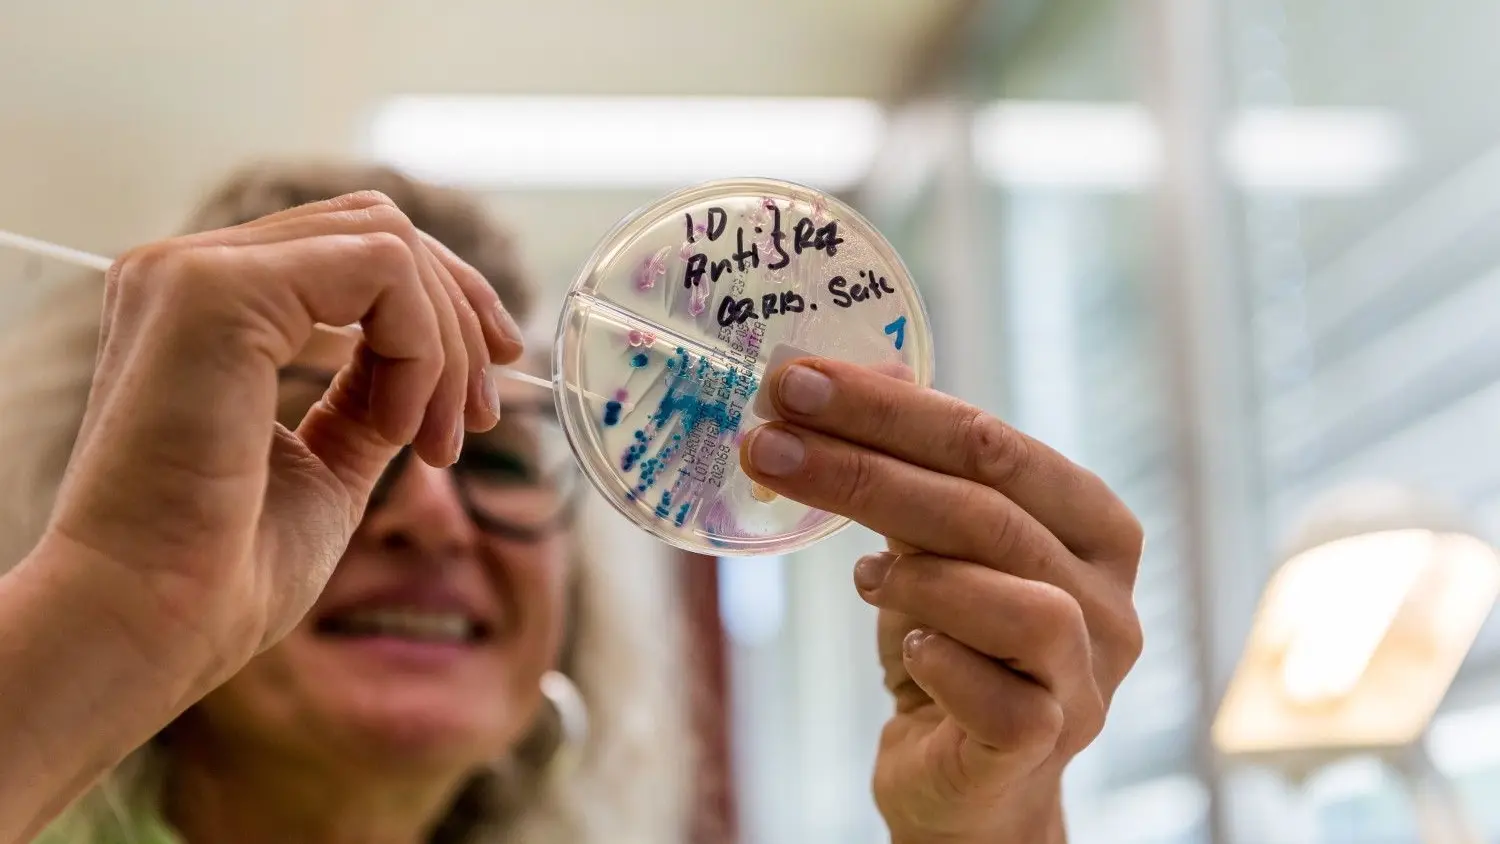

Alb-Fils-Kliniken Göppingen: Keime in der Klinik: Behörde erklärt Ausbruch für beendet
Drei Jahre lang kämpften die Alb-Fils-Kliniken gegen die multiresistenten VRE-Erreger. Die Behörden haben den Ausbruch jetzt offiziell für beendet erklärt.
Im Labor der Klinik am Eichert werden Proben auf Krankenhauskeime hin untersucht. Das Göppinger Gesundheitsamt hat nun offiziell das Ende des VRE-Ausbruchs in den Alb-Fils-Kliniken erklärt.
Giacinto Carlucci